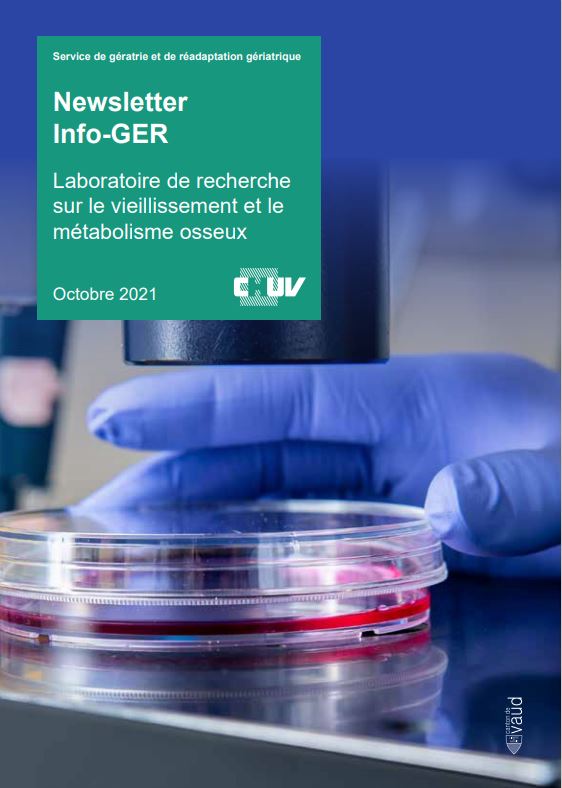

Newsletters
Les actualités en Gériatrie - Newsletter "Info-GER"

Numéro 27 - Mars 2023
Newsletter InfoGER
"L'unité de Long Séjour"

Numéro 28 - août 2023
Newsletter InfoGER
"La Fragilité"

Numéro 25 - Juillet 2022
Newsletter InfoGER
"La Mémoire"

Numéro 26-Octobre 2022
Newsletter InfoGER
"Unité d'Ortho-Gériatrie et consultations prétherapeutiques"

Numéro 24 - Avril 2022
Newsletter InfoGER
"L'Hôpital Adapté aux Aînés"

Numéro 23 - Janvier 2022
Newsletter InfoGER
"La Qualité de vie des Seniors"
Numéro 22 - Octobre 2021
Newsletter InfoGER
Laboratoire de recherche sur le vieillissement et sur le métabolisme osseux

Numéro 21 - Juin 2021
Newsletter InfoGER
"Les soignants de l'avenir - IPS"

Numéro 20 - Mars 2021
Newsletter InfoGER
"Pourquoi choisir la Gériatrie?"

Numéro 19 - Nov. 2020
Newsletter InfoGER
"La Fragilité chez les personnes âgées"

Numéro 18 - Juin 2020
Newsletter InfoGER
Remise en forme après le confinement

Numéro 17 - Mai 2020
Newsletter InfoGER
COVID-19 et prise en charge gériatrique

Numéro 16 - Mars 2020
Newsletter InfoGER
"La Gériatrie Aiguë"

Numéro 15 - Déc. 2019
Newsletter InfoGER
L'activité des Ergothérapeutes
Numéro 14 - Sept. 2019
Newsletter InfoGER
Succès & Distinctions

Numéro 13 - Avril 2019
Newsletter InfoGER
La Nutrition

Numéro 12 - Janvier 2019
Newsletter InfoGER - Chaire de Soins Palliatifs Gériatriques (CSPG)

Numéro 11 - Novembre 2018

Numéro 10 - Septembre 2018
Newsletter InfoGER "La Filières des Soins Aigus aux Seniors"

Numéro 9 - Avril 2018

Numéro 8 - Janvier 2018
Newsletter InfoGER - Centre de Gériatrie Ambulatoire et Communautaire

Numéro 7- Septembre 2017

Numéro 6 - Avril 2017

Numéro 5 - Janvier 2017

Numéro 4 - Septembre 2016

Numéro 3 - Mai 2016

Numéro 2 - Janvier 2016





